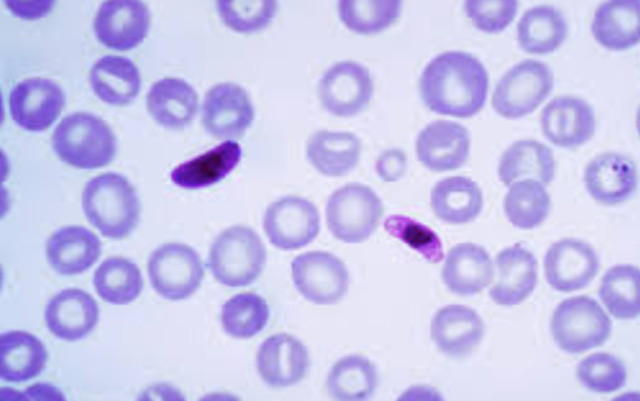
Plasmodium falciparum is described as the causative agent of malaria

-
Galen was one of the most prominent ancient physicians as well as a philosopher (though most of his philosophical writings are lost). Nonetheless, his philosophical interests are quite evident in his practice of biological science. Galen made some key anatomical observations.
-
In 1802 Lamarck made an outline about his theory on organic transformation. Lamarck’s theory is based on organic development that included it’s idea of how the very simplest forms of plants and animals life were actually the results of a spontaneous generation. He had two different sorts of causes. The first is called “The power of life” and the second is called the modifying influence of particular circumstances.
https://evolution.berkeley.edu/evolibrary/article/history_09 -
Gregor Johann Mendel was born on July 20th, 1822 in Czech Republic. He eventually became the abbot of St. Thomas' Abbey, after which his scientific work decreased due to increasing administrative responsibilities. Mendel is known for pea-plant experiments and subsequent theories on genetics. During a seven year period, Mendel experimented with pea plants in the garden owned in his monastery.http://www.dnaftb.org/1/bio.html
-
In 1831, there was a trip around the world. Charles Darwin was invited to join the HMS Beagle for a trip around the world. For about five years the ship survived the coast of South America. This allowed for Darwin to explore the contents as well as islands. For Darwin this was the most important event in his life, that allowed him to determined his whole career.
http://www.nationalgeographic.com.au/history/darwins-voyages.aspx -
Origin of species was published on November 21, 1859. It was based on a british naturalist named Charles Darwin, arguing about his theory about organism gradually evolve through a process he called Natural Selection. For Darwin to be able to prove his theory about organic evolution he went through a five year expedition in 1830’s.
https://www.allaboutscience.org/origin-of-species.htm -
In Paris in 1865 a chemist Louis Pasteur presented an experiment in front of his colleagues at the Paris Society for Chemistry that would turn the scientific world and much of what we believed on its head. Prior to Pasteur’s experiment, called “spontaneous generation” was a prevalent scientific method to explain how life came to be. This belief outlined that life can essentially arise from anything, even out of thin air.
https://www.britannica.com/biography/Louis-Pasteur/Spontaneous-generation -
After the discovery by Alphonse Laveran in 1880 that the causative agent for malaria was a parasite, detailed studies on these organisms commenced. The early detailed work of Golgi in 1886 demonstrated that in some patients there was a relationship between the 72-hour life cycle of development of the parasites and a similar periodicity of the paroxysm whereas in other patients there were 48-hour cycles of development.
http://www.123helpme.com/view.asp?id=44810//// -
In 1910, American geneticist Thomas Hunt Morgan peered through a hand lens at a male fruit fly, and he noticed it didn't look right. Instead of having the normally brilliant red eyes of wild-type Drosophila melanogaster, this fly had white eyes. Morgan was particularly interested in how traits were inherited and distributed in developing organisms, and he wondered what caused this fly's eyes to deviate from the norm.https://www.nature.com/scitable/topicpage/thomas-hunt-morgan-and-sex-linkage-452
-
Niels Bohr was one of the foremost scientists of modern physics, best known for his substantial contributions to quantum theory and his Nobel Prize-winning research on the structure of atoms. Bohr's greatest contribution to modern physics was the atomic model. The Bohr model shows the atom as a small, positively charged nucleus surrounded by orbiting electrons..
https://www.britannica.com/science/Bohr-atomic-model -
The Avery–MacLeod–McCarty experimentwas an experimental demonstration, reported in 1944 by Oswald Avery, Colin MacLeod, and Maclyn McCarty, that DNA is the substance that causes bacterial transformation, in an era when it had been widely believed that it was proteins that served the function of carrying genetic information.
https://www.yourgenome.org/stories/revealing-dna-as-the-molecule-of-life -
In May 1952, image of crystallizedDNA taken by Raymond Gosling. working as a PhD student under the supervision of Rosalind Franklin, at King's College London in Sir John Randall's group. It was critical evidence in identifying the structure of DNA.The photograph provided key information that was essential for developing a model of DNA.
http://blogs.discovermagazine.com/fire-in-the-mind/2013/04/25/on-dnas-anniversary-how-rosalind-franklin-missed-the-helix/#.WvDINdMvwnU -
n 1952, two scents named Alfred Hershey and Martha Chase published a conceiving demonstration about DNA, was a genetic material. Experiment Hershey-Chase was carried with a virus, that infects batch itself. This Virus is called Bacteriophage. This Virus contains a little more than just DNA packed inside a protein coat. Therefore, this virus is made of more than one material, that at that time was leading candidates for genetic material.
http://www.biology-pages.info/H/Hershey_Chase.html -
On this day in 1953, \Crick announce that they have determined the double-helix structure of DNA, the molecule containing human genes. Though DNA–short for deoxyribonucleic acid–was discovered in 1869, its crucial role in determining genetic inherit], According to their findings, DNA replicated itself by separating into individual strands, each of which became the template for a new double helix.
https://www.nature.com/scitable/topicpage/discovery-of-dna-structure-and-function-watson-397 -
In 1953 Matthew Meselsin and Franklin Stahl experiments on the replication of DNA, published in PNAS Meselson. Gave validity to a model that many scientists saw as speculation: how two intertwined and tangled strands of a helix could physically code for the material of inheritance.
\https://www.khanacademy.org/science/biology/dna-as-the-genetic-material/dna-replication/a/mode-of-dna-replication-meselson-stahl-experiment -
1960s, Marshall Nirenberg and National Institutes of Health colleagues focused on how DNA directs protein synthesis and the role ofRNA in these processes. Their 1961 experiment, using a syntheticmessenger RNA strand that contained only uracils, yielded a protein that contained only phenylalanines. Identifying UUU as the RNA code for phenylalanine was their first breakthrough.
http://www.scienceinschool.org/content/cracking-genetic-code-replicating-scientific-discovery -
This event was about American astronaut Neil Armstrong and American engineer Buzz Aldrin were the first to land on the moon. Finally after 4 days both NASA astronauts arrived at the moon on July 20 1969. The first steps were taken by Neil Armstrong , while taking the first step Neil Armstrong said “The Eagle has landed. That’s one small step for man, one giant leap for mankind”. https://airandspace.si.edu/explore-and-learn/topics/apollo/apollo-program/landing-missions/apollo11.cfm
-
In 1970, when Margulis's first book was published, most biologists had never heard of endosymbiosis. In order to succeed, Margulis had to carefully distinguish her ideas from the discredited theory proposed by Ivan Wallin half a century earlier. She had to overcome a basic assumption about evolution held by nearly all biologists at the time. According to the traditional view, evolution usually occurs gradually; endosymbiosis. changes.http://www.pnas.org/content/109/4/1022
-
In 1977, several groups of researchers who were working with adenoviruses that infect and replicate in mammalian cells obtained some surprising results. These scientists identified a series of RNA molecules that they termed "mosaics," each of which contained sequences from noncontiguous sites in the viral genome. Spliceosomes are huge, multimegadalton ribonucleoproteincomplexes found in eukaryotic nuclei.
https://www.nature.com/scitable/nated/article?action=showContentInPopup&contentPK=12375 -
In 1977, Frederick Sanger developed the classical “rapid DNA sequencing” technique, now known as the Sanger method, to determine the order of bases in a strand of DNA. Special enzymes are used to synthesize short pieces of DNA, which end when a selected “terminating” base is added to the stretch of DNA being synthesized.
https://www.sciencedirect.com/topics/neuroscience/sanger-sequencing -
in 1977, scientists exploring the Galápagos Rift along the mid-ocean ridge in the eastern Pacific noticed a series of temperature spikes in their data. They wondered how deep-ocean temperatures could change so drastically from near freezing to 400 °C. The scientists had made a fascinating discovery,deep-sea hydrothermal vents.
http://wwf.panda.org/about_our_earth/blue_planet/deep_sea/vents_seeps/ -
The Polymerase Chain Reaction technique, invented in 1985 by Kary B. Mullis, allowed scientists to make millions of copies of a scarce sample of DNA. The technique has revolutionized many aspects of current research, including the diagnosis of genetic defects and the detection of the AIDS virus in human cells. The technique is also used by criminologists to link specific persons to samples of blood or hair via DNA comparison.
https://www.karymullis.com/pcr.shtml -
In June 1988, Jennifer Wilson was on vacation from Yuma with her family, when she got kipnaped. 23 years after 9-year-old Jennifer Wilson was brutally raped and murdered and left on Flagstaff, the man convicted of killing her finally ran out of appeals. Richard Lynn Bible died by lethal injection at 11:11 a.m. Thursday in Florence for the 1988 murder.http://azdailysun.com/news/local/crime-and-courts/flagstaff-murderer-ricky-bible-executed/article_83b0572d-bc3e-57fc-95c5-a81f7484aecd.html
-
This research was funded in 1990.. This project is a two phase project that approaches to the human genome sequence. The first phase, is called the shotgun phase, this phase is divided human chromosomes into DNA segment to a appropriate size. The second phase is called the finishing phase, which involved with filling gaps and well as resolving DNA sequences in areas that were not obtained during the shotgun phase. http://science.sciencemag.org/content/291/5507/1304.full
-
The germ theory is about how certain diseases are caused by the invasion of the body by microorganisms that were too small to be seen except through a microscope. French chemist Louis Pasteure, English surgeon Joseph Lister and German physician Robert Koch were given credit for the development and acceptance of the theory. In mid 19th century French Chemist Louis showed that fermentedion and putrefaction are caused by organism in the air.
https://bigpictureeducation.com/history-germ-theory -
The Innocence Project was founded in 1992 by Barry C. Scheck and Peter J. Neufeld at the Benjamin N. Cardozo School of Law at Yeshiva University to assist prisoners who could be proven innocent through DNA testing. The Innocence Project’s groundbreaking use of DNA technology to free innocent people has provided irrefutable proof that wrongful convictions are not isolated or rare events but instead arise from systemic defects
https://content.law.virginia.edu/news/2009_spr/tj_medal.htm -
CRISPR-Cas9 is a genome editing tool that is creating a buzz in the science world. It is faster, cheaper and more accurate than previous techniques of editing DNA and has a wide range of potential applications. The CRISPR-Cas9 system consists of two key molecules that introduce a change into the DNA, enzymes and RNA. CRISPR was discover in 1993 at Francisco Monica, University of Alicante, in Spain. https://ghr.nlm.nih.gov/primer/genomicresearch/genomeediting
-
When Dolly was cloned in 1996 from a cell taken from a six-year-old ewe. The technique that was made famous by her birth is somatic cell nuclear transfer, in which a cell is placed in a de-nucleated ovum, the two cells fuse and then develop into an embryo. She was cloned at the Roslin Institute in Midlothian, Scotland, and lived there until her death when she was six years old.http://dolly.roslin.ed.ac.uk/facts/the-life-of-dolly/index.html
-
This definition of evolution was developed largely as a result ofindependent work in the early 20th century by Godfrey Hardy, an English mathematician, and Wilhelm Weinberg, a German physician. Through mathematical modeling based on probability, they concluded in 1908 that gene pool frequencies are inherently stable but that evolution should be expected in all populations virtually all of the time.
http://www.biologyreference.com/Gr-Hi/Hardy-Weinberg-Equilibrium.html -
In 2001 a strange fossil was discovered. After research team of scientist led by a french paleontologist found this fossil, they soon discovered that this fossil is one of the oldest known species in the human family tree. Although the only evidence they have about this species is just the cranial. What they discovered where that this species had a ape like as well as a human like feature. http://humanorigins.si.edu/evidence/humanfossils/species/sahelanthropus-tchadensis
-
This experiment led Griffith to conclude that the dead the Type II-R bacteria had been transformed by the Type III-S bacteria enabling it to develop a polysaccharide cover and take on its virulent properties.This meant that the bacterial strains did not have fixed and non-interchangeable properties, which was the thinking at the time. They were capable of transformation and this clearly indicated gene transfer.
https://biologywise.com/frederick-griffiths-experiment-concept-of-transformation
Looking for a timeline maker?
Create timelines for projects, roadmaps, history, lessons, legal cases, and stories with Timetoast. Timetoast is a timeline maker for work, school, research, and stories.